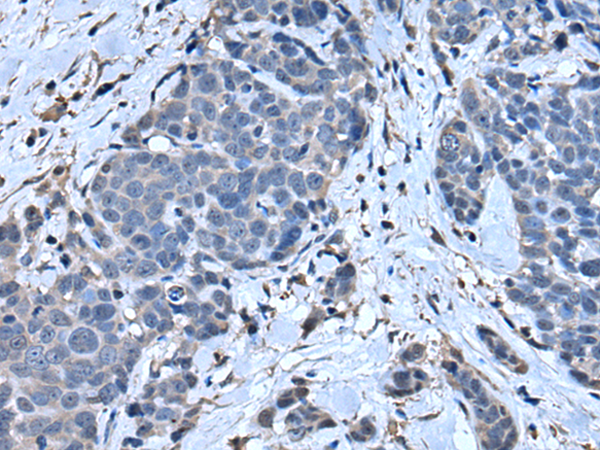

-
分类: 科研抗体货号: P01786别名: DIFF6; NEDD5; SEPT2; NEDD-5; Pnutl3; hNedd5应用: WB,IHC反应种属: Human, Mouse, Rat
-
分类: 科研抗体货号: P01785别名:应用: WB反应种属: Human, Mouse, Rat
-
分类: 科研抗体货号: P01814别名: ALP; MPI; ALK1; BLPI; HUSI; WAP4; WFDC4; HUSI-I应用: IHC反应种属: Human
-
分类: 科研抗体货号: P01783别名:应用: IHC反应种属: Human, Mouse
-
分类: 科研抗体货号: P01856别名: MED24; SURF5; surf-5应用: IHC反应种属: Human, Mouse, Rat
-
分类: 科研抗体货号: P01811别名:应用: WB,IHC反应种属: Human, Mouse
-
分类: 科研抗体货号: P01777别名: DCE; SELADIN1; Nbla03646; seladin-1应用: WB,IHC反应种属: Human, Mouse, Rat
-
分类: 科研抗体货号: P01854别名: HSST2应用: WB,IHC反应种属: Human
-
分类: 科研抗体货号: P01806别名: ORC2; ORNT2应用: IHC反应种属: Human
-
分类: 科研抗体货号: P01776别名: RBT1应用: IHC反应种属: Human, Mouse

鄂公网安备42018502007531号
鄂公网安备42018502007531号

